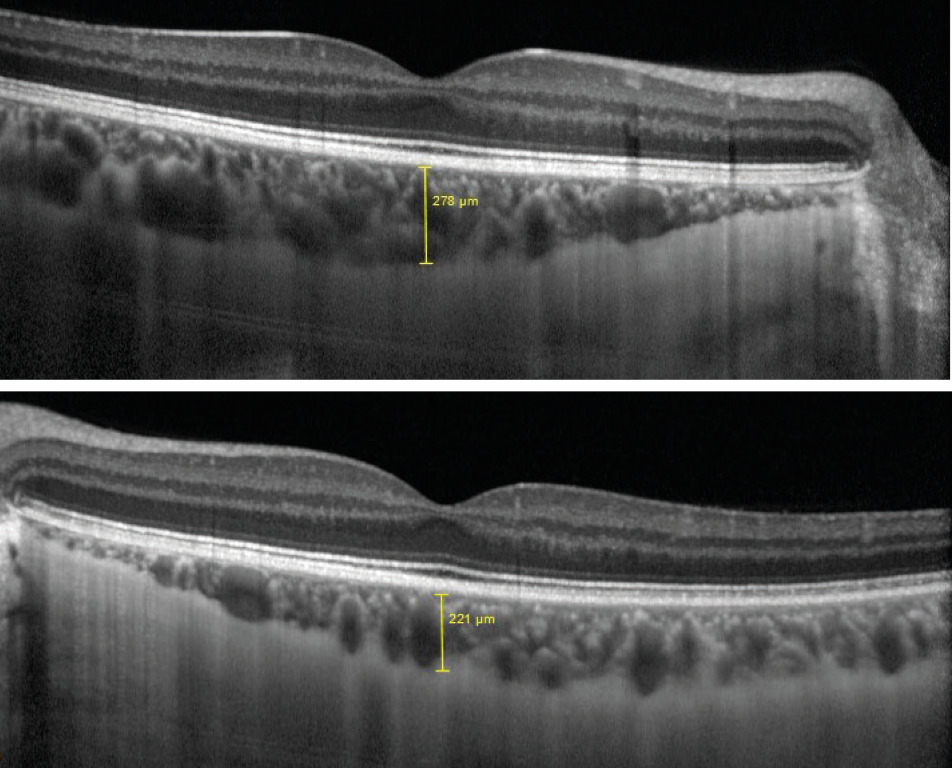

Rev Bras Oftalmol.2021;80(2):96-99
Evaluation of choroidal thickness and retinal nerve fiber layer thickness in patients with unilateral amblyopia: a prospective study
DOI: 10.5935/0034-7280.20210018
ABSTRACT
Purpose:
to compare the Subfoveal choroidal thickness (SFCT) and Retinal Nerve Fiber Layer Thickness (RNFL) of amblyopic and normal fellow eyes. Design: Prospective, cross-sectional, observational case series.
Methods:
Forty patients age 12 to 41 years (mean 23.73 ± 6.42) with unilateral amblyopia were studied. Among them, 11(28.2%) patients had amblyopia secondary to strabismus and 29(71.8 %) had anisometropic amblyopia. Optical coherence tomography (OCT) of the peripapillary RNFL thickness of amblyopic and fellow eyes was performed. RNFL thickness measurements were taken from the superior, inferior, nasal and temporal quadrants in the peripapillary region. Also, subfoveal choroidal thickness (SFCT) was measured using spectral domain optical coherence tomography (SD-OCT).
Results:
Mean global RNFL thickness of the amblyopic and fellow eyes was 104.48 microns and 102.83 microns, respectively. The difference between the two groups was not statistically significant (p>0.05%). The thicknesses of the superior, inferior, nasal and temporal quadrants of the retinal nerve fiber layer between the amblyopic and normal fellow eyes showed no statistically significant difference (p>0.05%). However, the SFCT of amblyopic eye was 11 or more microns thicker than the fellow eye and this was statistically significant different (p<0.05%).
Conclusions:
This study demonstrated SFCT in amblyopic eyes was significantly thicker than the normal fellow eyes. The amblyopic process may involve the choroid, but not the prepapillary NFL.